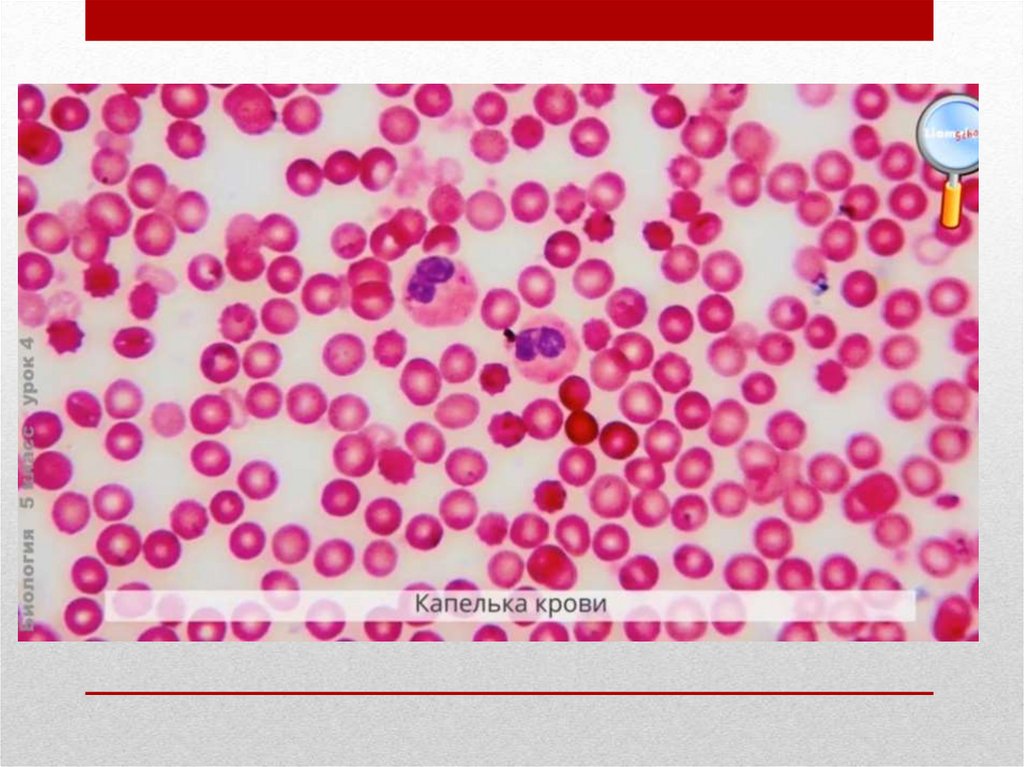

Similar presentations:
Увеличительные приборы
1.
Тема: Увеличительные приборы2.
Лупа – самый простойувеличительный прибор
Увеличение в 2-25 раз
3.
4.
5.
6.
7.
8.
9.
Электронный микроскоп дает увеличениев 1 млн. раз
10.
11.
12.
Флуоресцентный микроскоп13.
Клетки стенок кровеносного сосуда,окрашенные флуоресцентными
красителями
14.
Лабораторная работа №1«Изучение строения
увеличительных приборов»
15.
16.
Домашнее задание1. Параграф 4 (стр. 15-18)
Интернет ресурсы: страница «ВКонтакте»